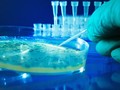
ADN của cơ thể có thể là nơi lưu trữ dữ liệu

Nghiên cứu chỉ ra cơ sở sinh học của những bệnh liên quan đến tâm thần, từ đó có thể đưa ra những biện pháp chữa trị tốt hơn.
Khi bạn bị ngã gãy xương, chụp X-quang sẽ tìm ra chỗ gãy. Nhưng không có nhiều phương pháp phát hiện những rối loạn não bộ. Vì thế, rất khó để tìm ra cách chữa bệnh cho hàng triệu người mắc chứng lo âu hay rối loạn ám ảnh cưỡng chế.
Tuy nhiên, một nghiên cứu gần đây đã thay đổi điều đó. Các nhà khoa học đã xác định được một trong những đặc tính di truyền nổi bật của bệnh tâm thần. Khám phá này có thể sẽ thay đổi phương pháp tiếp cận để điều trị những rối loạn đó. Nếu hiểu rõ hơn về gen đặc biệt là những gen ảnh hưởng trực tiếp tới rối loạn tâm thần, chúng ta có thể xác định chính xác phần não bộ bị ảnh hưởng.
Năm ngoái, Roy Perlis, Giám đốc Trung tâm thuốc thử nghiệm và chẩn đoán, bệnh viện đa khoa Massachusetts nói với tờ Business Insider rằng: “Ngoài việc nghiên cứu những dữ liệu, tôi nghĩ rằng việc chỉ ra trầm cảm là một căn bệnh về não và tìm ra những yếu tố sinh học tác động đến nó là vô cùng quan trọng.” Ông nói thêm: “Chúng là những căn bệnh của não bộ và giống như bất kỳ loại bệnh nào khác, không phải là lỗi của ai đó”.
 Ảnh: Business Insider
Ảnh: Business Insider
Nghiên cứu mới đây nhất chỉ ra rằng ADN đóng vai trò chính trong việc hình thành những rối loạn tâm thần. Bệnh tâm thần có nguy cơ truyền từ cha mẹ sang con cái. Đây là một phát hiện quan trọng sau hàng thập kỉ nghiên cứu của các nhà khoa học. Elinor Karlsson, nhà di truyền học thuộc Viện nghiên cứu Broad của Viện công nghệ Massachusetts (MIT) và Đại học Harvard nói với tờ Business Insider rằng: “Di truyền đóng vai trò rất lớn trong nguy cơ mắc những căn bệnh này”. Tuy nhiên, nếu chỉ nhìn vào cấu trúc gen của ai đó có lẽ sẽ không bao giờ đủ để xác định liệu họ sẽ mắc bệnh tâm thần hay không. Các yếu tố khác bao gồm yếu tố môi trường như căng thẳng kéo dài cũng là tác nhân gây bệnh. Bên cạnh đó, các nhà khoa học vẫn đang không ngừng nỗ lực tìm ra chìa khóa mở ra những phương pháp điều trị mới cho rối loạn thần kinh, những phương pháp này sẽ tập trung sâu hơn vào ADN của chúng ta.
Karlsson nhấn mạnh: “Chúng ta cần theo dõi sát sao thành phần di truyền này”.
Nhiều khả năng những người mắc chứng rối loạn ám ảnh cưỡng chế bị đột biến những gen này.
Hyun Ji Noh, nhà di truyền học tại Viện nghiên cứu Broad, đã đọc rất nhiều tại liệu về mối liên kết giữa triệu chứng rỗi loạn ám ảnh cưỡng chế và di truyền học. Mặc dù đây đều là những nghiên cứu đầy hứa hẹn, nhưng không nghiên cứu nào chỉ ra cụ thể gen nào gắn liền với rối loạn này.
Vì thế, trong nghiên cứu gần đây nhất của mình được xuất bản hồi đầu tháng trên tạp chí Nature Communications, cô áp dụng một phương pháp mới.
Thay vì chỉ tập trung vào ADN của người, cô xem xét nhiều bộ gen từ những loài khác.
Trong buổi phỏng vấn với tờ Business Insider, cô nói rằng: “ở loài chó, có rất nhiều căn bệnh do tự nhiên đặc biệt là những chứng bệnh liên quan đến thần kinh, điều này tương tự như loài người. Vì thế, những nghiên cứu về loài chó có thể hữu ích trong việc nghiên cứu những căn bệnh của loài người.”
Nghiên cứu của Noh đã khảo sát hàng trăm gen liên quan đến bệnh tâm thần ở chó, chuột và người.
Các nhà nghiên cứu tìm ra 608 gen ở người. Để tìm ra gen nào trong số 608 gen có liên quan đến OCD, Noh đã so sánh hình dạng của chúng ở những người bình thường và những người mắc OCD. Sau khi phân tích kết thúc, chỉ có 4 gen bị đột biến ở nhưng người mắc chứng OCD.
 Ảnh: Business Insider
Ảnh: Business Insider
Noh nói rằng trong số 4 gen này “rất nhiều đột biến xuất hiện ở những người mắc chứng rối loạn ám ảnh cưỡng chế nhưng không xuất hiện ở những người bình thường”.
Nói cách khác, 4 gen này đóng vai trò then chốt trong cơ chế sinh học của rối loạn này. Tuy nhiên, nếu chỉ một trong 4 gen này bị đột biến thì khả năng mắc rối loạn là rất thấp.
Truy tìm gen gây trầm cảm
Các nhà khoa học chỉ ra rằng ADN cũng là tác nhân dẫn tới bệnh trầm cảm. Nhưng không giống như OCD, nó phổ biến hơn vì theo ước tính có khoảng 16,1 triệu người Mỹ mắc bệnh này. Những phương pháp điều trị trầm cảm không thay đổi kể từ những năm 1950 và không phải bệnh nhân nào cũng khỏi bệnh nếu chỉ áp dụng những phương pháp ấy.
Vì vậy, để tìm hiểu chính xác nguyên nhân của căn bệnh, các nhà nghiên cứu đã viết một bài báo trên tạp chí Nature Genetics vào mùa hè năm ngoái. Bài báo đã xác định 17 cặp biến thể di truyền và những thay đổi trong những gen đặc biệt mà có liên quan nhất tới những rối loạn trầm cảm, nguyên nhân hàng đầu gây ra khuyết tật trên toàn Thế giới.
Các nhà nghiên cứu đã thu thập dữ liệu từ công ty gen 23andMe.
Họ đã sử dụng dữ liệu từ hơn 75,600 người đã được chẩn đoán mắc chứng trầm cảm và hơn 231,700 người không có tiền sử trầm cảm. Perlis và nhóm nghiên cứu của mình đã xác định 17 vùng trên ADN có liên quan tới trầm cảm. Họ cũng tìm ra mối quan hệ giữa 17 vùng này với những vùng khác trên ADN mà có khả năng gây ra những rối loạn tâm thần khác như bệnh tâm thần phân liệt.
Các nhà khoa học vẫn đang miệt mài tìm kiếm những dấu hiệu di truyền của chứng trầm cảm trong hàng năm trời. Mặc dù có một số nghiên cứu đầy hứa hẹn như bài nghiên cứu đăng trên tạp chí The Lancet năm 2013, và bài báo của tạp chí Nature năm 2015, nhưng cho tới thời điểm hiện tại, chưa nghiên cứu nào chỉ ra chính xác dấu hiệu di truyền của chứng bệnh.
Perlis nói rằng: “Nhóm của tôi đã tìm kiếm yếu tố di truyền là tác nhân của trầm cảm trong một thập kỉ mà chưa thành công, vì thế chúng tôi vô cùng vui sướng khi những nỗ lực không ngừng nghỉ cuối cùng được đền đáp”.
Hi vọng rằng kết quả của những nghiên cứu trên sẽ giúp chúng ta hiểu rõ hơn về cách thức di truyền và hành vi tương tác ảnh hưởng tới rối loạn như bệnh trầm cảm.
Tuy nhiên Perlis cho rằng: “Đây mới chỉ là khởi đầu. Công việc khó khăn bây giờ là tìm ra những phương pháp điều trị mới cho những rối loạn thần kinh nêu trên”.